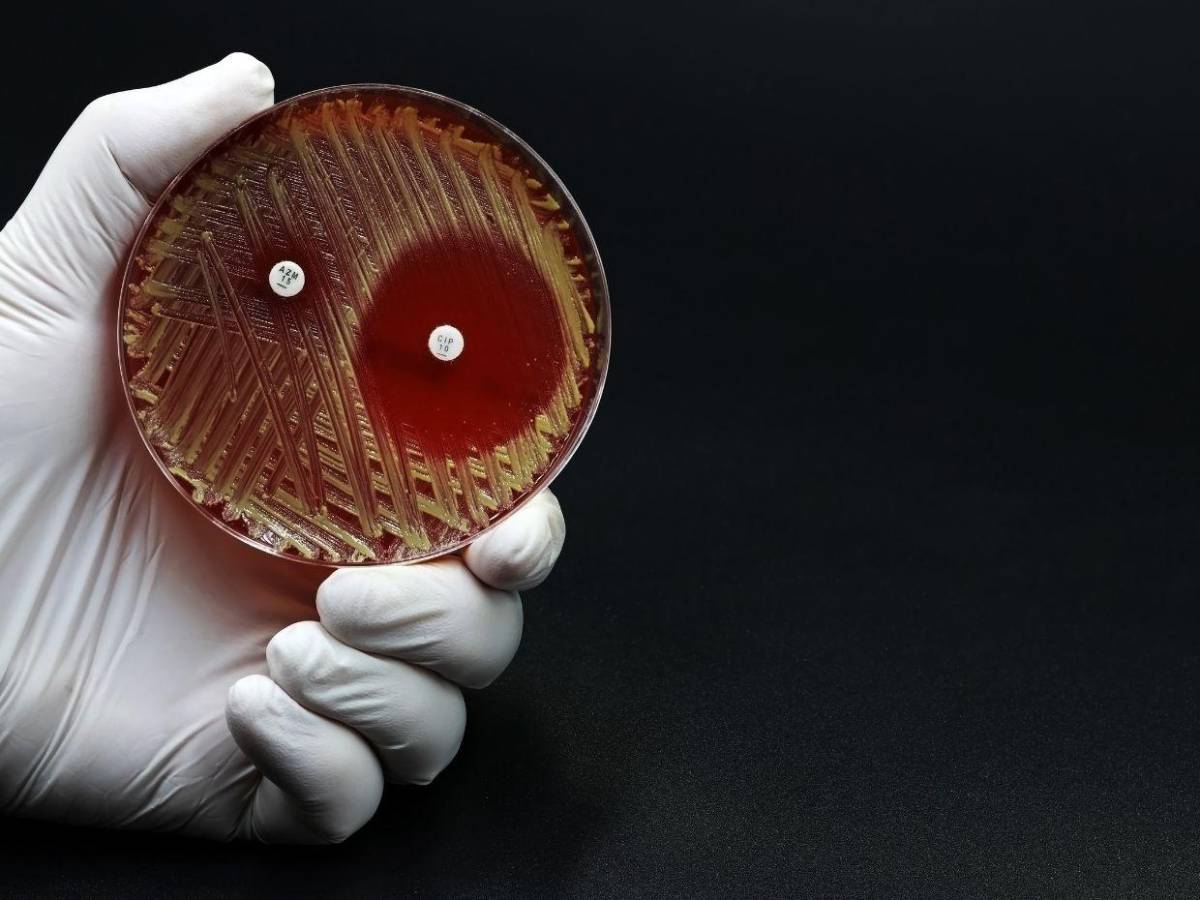
¿Qué son las “bacterias espejo” y por qué amenazarían la vida en la Tierra?
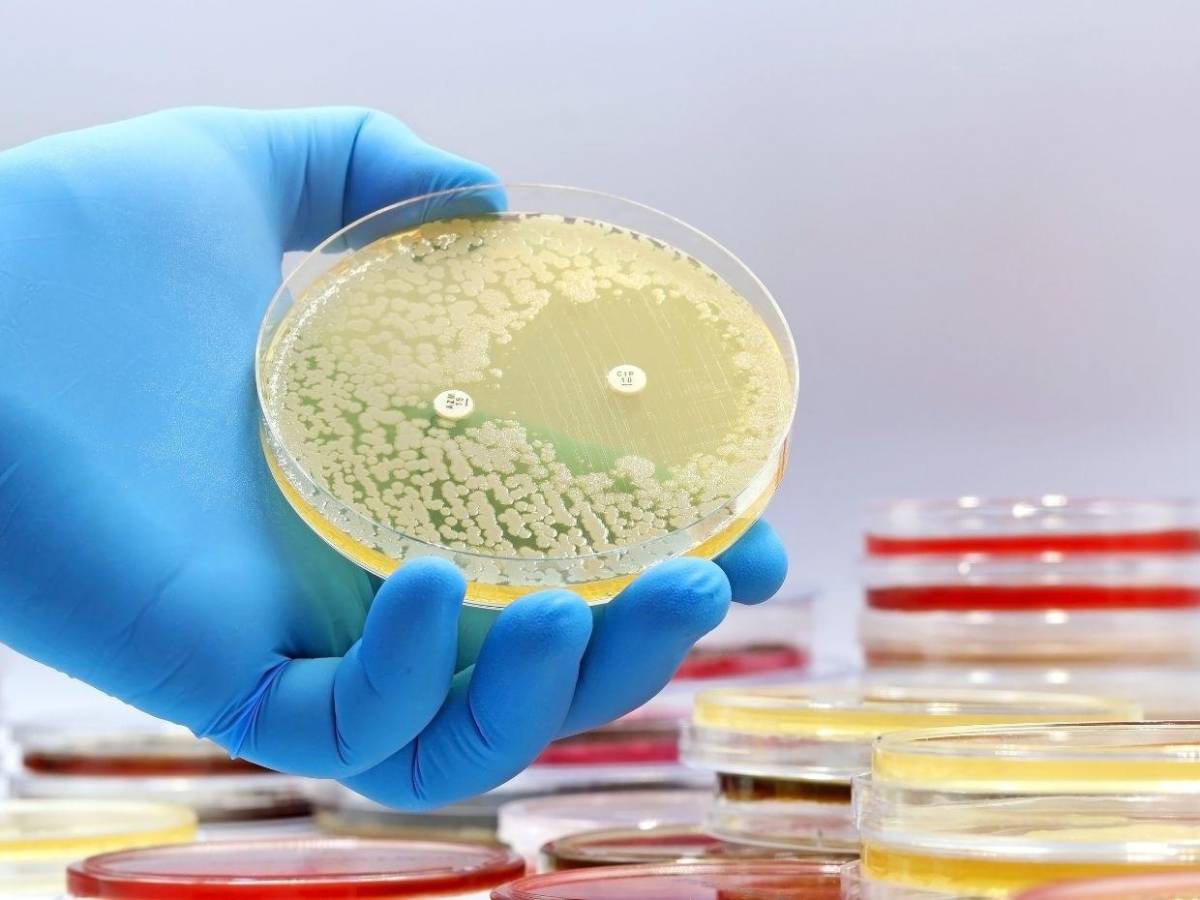
¿Qué son las “bacterias espejo” y por qué amenazarían la vida en la Tierra?

¿Qué son las “bacterias espejo” y por qué amenazarían la vida en la Tierra?
Aunque prometen avances en medicina y biotecnología, estas bacterias podrían evadir los sistemas inmunológicos y proliferar sin control, amenazando la biodiversidad y sectores clave.
- Actualizado: 13 de diciembre de 2024 a las 00:00

Los avances científicos en biología sintética han llegado a altos niveles con la creación de organismos diseñados a partir de moléculas con quiralidad invertida, a estas se les conoce como “bacterias espejo”.

Estas poseen un gran potencial en campos como la biotecnología o la medicina, de acuerdo a los institutos médicos que la vienen desarrollando.
Sin embargo, los avances en “bacterias espejo” mantiene preocupados a varios científicos que alertan sobre el peligro de seguir investigándolas porque pueden presentar un “riesgo sin precedentes” para la vida en la Tierra.

La revista de divulgación científica ‘Science’, expertos en la materia, instan a detener todos los proyectos que están investigando con ellas para evitar malos mayores en un futuro cercano.

Cada destacar que las bacterias espejo son prácticamente idénticas a las ya conocidas que se crean en laboratorios mediante técnicas de biología sintética.

Esto consiste en que los investigadores identifican las moléculas que quieren replicar y tras seleccionarla, crean nuevas moléculas con la misma composición química, pero con una estructura tridimensional invertida, como si se vieran en un espejo.

Los peligros de las bacterias espejo radican en que se modifica genéticamente las bacterias, para que se puedan utilizar en sus procesos biológicos.

Al ser distintas a las bacterias normales, nuestro sistema inmunológico no reconoce de inmediato a las bacterias espejo cuando entran en nuestro organismo y le cuesta mucho más combatirlas.

Al no ser rápidamente reconocidas por el organismo, permiten que se conviertan en una gran herramienta para desarrollar nuevos fármacos y terapias más eficaces.
Pero es esto lo que preocupa a los expertos que advierten que, del mismo modo, al no ser detectadas por el organismo, podrían evadir cualquier sistema inmunológico conocido y proliferar sin control en el ambiente.

Vaughn Cooper, de la Universidad de Pittsburgh, cuestiona que su dispersión sería imposible de detener, causando graves daños a la biodiversidad y a sectores clave como la agricultura.

Ante esos riesgos, los autores del estudio instan a detener toda investigación orientada a crear este tipo de organismos sintéticos y piden regulaciones globales inspiradas en modelos como las Directrices de Bioseguridad de Tianjin, para evitar el desarrollo de tecnologías que puedan facilitar su creación.